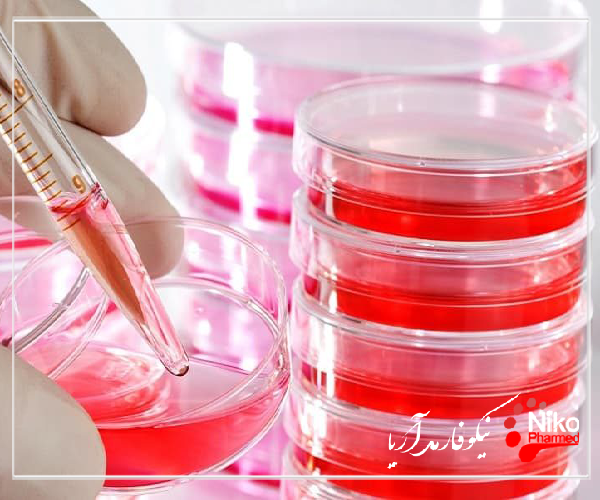
m/تست بایو بودن

تست بایوبردن
تست ایمنی زیستی و زیست سازگاری
خصوصیات شیمیایی مواد
به عنوان بخشی از ارزیابی بیولوژیکی دستگاه های پزشکی،نیکوفارمد خدمات مشخصه های برای انواع تست های شیمیایی را ارائه می دهد.
برای کسب اطلاعات بیشتر و دریافت خدمات با ما تماس بگیرید.
در حالی که روشها و مفاهیم تحلیلی با مطالعات قابل استخراج و آب شوئی برای ظروف و سیستمهای بسته بندی سازگار است، راه حلهای سریع و مقرون به صرفه برای مقایسه محصولات دستگاههای پزشکی پس از تغییرات طراحی و مواد و همچنین تغییر مواد اولیه، مقدار تولید یا کهنگی مورد نیاز است.
برای دستیابی به این هدف، ما از «اثر انگشت GC/HPLC/ICP» استفاده میکنیم، یک سرویس تحلیلی استاندارد با در نظر گرفتن مواد موجود و دادههای تولیدی که منجر به خصوصیات شیمیایی کامل محصولات دستگاههای پزشکی میشود.
در برخی شرایط یک طرح کلی مطالعه سفارشی برای تکمیل مشخصات و ارزیابی ایمنی دستگاه توصیه می شود. به لطف تخصص ما در زمینه تجهیزات پزشکی و بسته بندی دارویی، ما قادر خواهیم بود از شما در طراحی یک پروتکل مطالعه مناسب (دما و مدت استخراج، شبیهسازهای مورد استفاده و غیره) برای ارزیابی تحلیلی مواد قابل استخراج و سم شناسی آنها حمایت کنیم.
کنترل بار زیستی در حال حاضر در زمینه های مختلف تولید دارو و بیودارو و کنترل کیفیت نقش دارد. آزمایش بار زیستی یک جنبه مهم از نظارت بر کنترل کیفیت قبل از استریل کردن (و اعتبار سنجی یا اعتبار سنجی مجدد)، نظارت بر مواد خام، نظارت بر محیط زیست و کنترل فرآیندهای تولید است. Biobburden اصطلاحی است که برای توصیف جمعیت ذاتی میکروارگانیسم های موجود در یک محصول استفاده می شود. مسیرهای متعددی وجود دارد که در آن یک محصول می تواند بار زیستی میکروبی را به دست آورد، مانند مواد خام، فرآیندهای تولید و بسته بندی.
انجام آزمایش بایوبردن به سازنده اجازه می دهد تا تشخیص دهد که آیا در فرآیندهای خود مشکلی وجود دارد یا خیر، و به آنها اجازه می دهد تا اقدامات مربوطه را برای اطمینان از استریل شدن کامل محصول انجام دهند. تخمین بار زیستی در دستگاه های پزشکی به طور خاص می تواند چالش برانگیز باشد، به دلیل ساختار و ترکیب آنها، که می تواند از دستگاهی به دستگاه دیگر بسیار متفاوت باشد.
در سال های اخیر، رشته میکروبیولوژی دارویی پیشرفت های تکنولوژیکی متعددی را تجربه کرده است که با انتشار روش های تکمیلی جدید و هماهنگ همراه شده است. بنابراین برای کسانی که مسئول نظارت بر کیفیت میکروبی محصولات دارویی/بیودارویی هستند ضروری است که از آخرین تغییرات مطلع شوند.
اصل آزمون بایوبردن
جمعیت میکروارگانیسم های زنده (بایوبردن) در یک محصول یا روی سطح محصول برای نظارت بر فرآیند تولید، چه برای یک محصول دارویی و چه برای یک دستگاه پزشکی، مورد نیاز است. در اغلب موارد، با یک محصول دارویی، فرد به طور مستقیم محصول را بررسی می کند، در این صورت نیاز به اطمینان از عدم وجود خواص ضد میکروبی در محصول وجود دارد تا بر نتایج تأثیر بگذارد. این معمولاً توسط آزمایشهای بازیابی میکروارگانیسم ها انجام می شود. در مورد دستگاه های پزشکی این احتمال وجود دارد که روش استخراج ممکن است تمام میکروارگانیسم ها را از دستگاه حذف نکند و در نتیجه باعث دست کم گرفتن بار زیستی واقعی موجود شود. بنابراین نیاز به ایجاد یک ضریب تصحیح برای دستگاه خاص مورد مطالعه وجود دارد. برای روش های ایجاد ضریب تصحیح دو رویکرد وجود دارد که می توان از آنها استفاده کرد. اینها بر اساس استاندارد ISO هستند.
برای دستگاه های پزشکی بایوبردن طبیعی پیش بینی شده ، یک درمان تکراری استفاده می شود. دستگاه با رقیق کننده شسته شده و فیلتر می شود و چندین بار تکرار می شود تا زمانی که میکروارگانیسم های کوچکی پیدا نشوند یا بسیار اندک باشند. تعداد کلنی های بازیابی شده پس از فیلتر اولیه روش حذف به عنوان کسری از تعداد کل کلنی های شمارش شده بیان می شود. سپس این کسر به عنوان ضریب تصحیح برای تمام آزمایشات بعدی آن دستگاه با آن روش اعمال می شود. سپس نتیجه معمول به عنوان تخمین بار زیستی بیان می شود، که نشان دهنده تعداد بار زیستی شناسایی شده ضرب در ضریب تصحیح است.

تست بایوبردن و روشهای میکروبیولوژی سریع
هرچه اندازه گیری آلودگی میکروبی در سیستم های آب ، مواد خام یا محصولات نهایی آسان تر و سریع تر باشد ، توانایی شما برای تصمیم گیری سریع تر که بر ایمنی و کیفیت تأثیر می گذارد، بهتر است. در فرآیند های تولید و تصفیه تجهیزات دارویی و پزشکی ، این امر برای ایمنی بیمار ، انطباق با مقررات و کارایی فرآیند بسیار مهم است.
برای اطمینان از ایمن بودن یک محصول دارویی برای بیماران ، تعیین بار زیستی آن در یک آزمایش کنترل کیفیت کاملاً تنظیم شده الزامی است. آزمایش بار زیستی (یا آزمایش حد میکروبی) تعداد باکتری ها ، مخمرها و کپک های در حال رشد هوازی را بر روی سطوح یا در محلول هایی مانند مواد خام ، مواد واسطه ای فرآیند و محصولات نهایی کمیت می دهد. در حالی که از منظر ایمنی محصول ضروری است ، آزمایش بار زیستی یک گلوگاه در جدول های زمانی عملیاتی است و تولید کنندگان باید تا پنج روز برای نتایج آزمایش روش تکمیلی منتظر بمانند. در این دوره ، مراحل بعدی پردازش اغلب شروع نمی شود یا محصول نهایی به بازار عرضه نمی شود ، در حالی که هزینه های ذخیره سازی افزایش می یابد و بیماران احتمالاً باید منتظر بمانند. بنابراین تمایل محسوسی برای کاهش زمان رسیدن به نتیجه وجود دارد.
چرا آزمایش بایوبردن اینقدر طول می کشد؟
بار زیستی باید در فرآیند های تولید استریل و غیراستریل تعیین شود. برخی از محصولات مانند مواد تزریقی باید استریل باشند. برای داروهای غیر استریل ، از لوسیون های پوستی گرفته تا قرص های معمولی ، آستانه های خاصی وجود دارد که نباید از آنها تجاوز کرد. این محدودیت ها متفاوت است و به محصول و کاربرد مورد نظر آن و همچنین به میکروارگانیسم های مورد نظر بستگی دارد. این فهرست میکروارگانیسم هایی را که باید برای اعتبارسنجی روش و کشت مورد استفاده قرار گیرند ، نشاندهنده باکتری های گرم مثبت و گرم منفی ، مخمرها و کپک ها فهرست می کند. با این حال، این موارد لزوماً منعکس کننده وضعیت در محل نیستند ، بنابراین اغلب توسط نهاد نظارتی به عنوان یک امتیاز مثبت در نظر گرفته می شود که به دنبال سویه های داخلی که احتمال بیشتری روی محصول یافت می شوند ، تأیید شود.
چرا آزمایش بایوبردن مهم است؟
آزمایش بار زیستی درست قبل از فرآیند استریل سازی نهایی برای یک دستگاه یا محصول پزشکی انجام می شود و سطح آلاینده های موجود بر روی قطعه را اندازه گیری می کند.
آزمایش بار زیستی از اهمیت بالایی برخوردار است زیرا بینشی در مورد سطح و شدت استریلیزاسیون مورد نیاز ارائه می دهد و انتخاب روش استریلیزاسیون را به اطلاع می رساند. فرآيند استريليزاسيون نهايي آخرين مانع حفاظتي قبل از رسيدن دستگاه به بيماران و كاربران است و مهم ترين گام در جلوگيري از ايجاد آسيب آلاينده هاي ناخواسته است. آزمایش بار زیستی و عقیم سازی مناسب به ویژه در صنعت پزشکی ، که در آن بیماران در برابر عفونت یا بیماری آسیب پذیر هستند ، مهم است.
تست بایوبردن به ما چه می گوید؟
نتایج آزمایش بار زیستی اطلاعات کلیدی را برای تعدادی از کاربردهای مختلف ارائه می دهد. این شامل:
انتخاب فرآیند استریل سازی مناسب: با درک بهتر از انواع آلاینده ها و در چه سطوحی ، مهندسان بهتر می توانند مؤثرترین فرآیند و روش استریل سازی را تعیین کنند.
به دست آوردن بینش در مورد فرآیند تولید: نتایج غیرمنتظره در آزمایش بار زیستی می تواند بینش ارزشمندی را در مورد فرآیند تولید، از جمله هر گونه مسائل که ممکن است آلاینده های غیر ضروری به محصول وارد کند ، ارائه دهد.
محافظت از دستگاه: آزمایش بار زیستی به اطمینان از انتخاب روش صحیح استریلیزاسیون کمک می کند ، هم از نظر حذف آلاینده ها و هم از استفاده از روش هایی که ممکن است نامناسب یا ناسازگار با دستگاه باشد. به عنوان مثال ، برخی از روش های استریل سازی ممکن است در دمایی که برای مواد خاص بسیار بالا است ، رخ دهد که می تواند به دستگاه آسیب برساند و کارایی و ایمنی آن را کاهش دهد.
آزمایش بار زیستی را می توان برای سطح مقطع وسیعی از انواع آلاینده استفاده کرد، از جمله:
باکتری های هوازی
باکتری های بی هوازی
هاگ
قارچ
مقالات بیشتر:
فرآیند تست بایوبردن چیست؟
فرآیند آزمایش بار زیستی شامل چندین مرحله است که هر کدام باید برای اطمینان از صحت، اعتبار و اثربخشی فرآیند دنبال شود. همچنین توجه به این نکته مهم است که در حالی که آزمایش بار زیستی همیشه باید به عنوان آخرین مرحله قبل از فرآیند استریلیزاسیون پایانه انجام شود، می تواند در هر نقطه دیگری از فرآیند تولید نیز رخ دهد
آزمایش بار زیستی می تواند در چندین زمینه مختلف از فرآیند تولید تجهیزات پزشکی مفید باشد ، از جمله:
تست تامین آب
کنترل کیفیت از طریق آزمایش نمونه تولید تصادفی
آزمایش قبل از عقیم سازی
آلودگی زدایی بحرانی

تست بایوبردن در فرآیند داروها
آزمایش بار زیستی در فرآیند برای تجزیه و تحلیل مقادیر و انواع میکروارگانیسم ها در فرآیند تولید انجام می شود. برای اینکه داده ها دقیق باشند، روش باید به درستی توسعه یافته و اعتبار سنجی شود. روند داده ها مفید است زیرا می توان از آن برای نظارت بر روندهای نامطلوب ، نوسانات فصلی و حتی بار میکروبی فیلترهای استریل کننده استفاده کرد. اما ، این همه چیز نیست. اغلب داستانی با داده ها وجود دارد - داستانی که می تواند حکایت محتمل ترین علت ریشه ای را در طول یک تحقیق خارج از مشخصات داشته باشد و می تواند شواهدی از آلودگی غیرعمدی یا بیوفیلم های چرک زده کشف نشده را نشان دهد.
مروری بر آزمون بایوبردن در فرآیند
سنجش بایوبردن برای آزمایش در حین فرآیند داروها برای درک انواع و مقادیر میکروارگانیسم های موجود در محصول در طول فرآیند تولید ، مرکزی است. این آزمایش ، باکتری ها و قارچ های مزوفیل هوازی را غربال می کند و داده های به دست آمده یک نشانه اولیه از کیفیت محصول نهایی را نشان می دهد. به عنوان مثال ، می توان از داده های به دست آمده استنباط کرد که محصول نهایی بدون مواد میکروبی خارجی ، برای مصرف کننده بی خطر است ، و به طور بالقوه ، محصول همانطور که در نظر گرفته شده است ، واکنش نشان می دهد.
برخی از میکروارگانیسم ها می توانند تأثیر نامطلوبی بر فعالیت محصولات (یعنی کاهش یا غیرفعال کردن) داشته باشند و بر سلامت بیماران تأثیر بگذارند. اعتبارسنجی مناسب تست بایوبردن برای اطمینان از دقیق بودن نتایج ضروری است. علاوه بر این ، اگر آزمایش ها انجام نشوند یا به درستی تایید نشده باشند ، یا اگر داده های به دست آمده به درستی بررسی نشده باشند ، میکروارگانیسم های قابل اعتراض ممکن است شناسایی نشوند. اگر داده ها به درستی بررسی نشود ، ممکن است خطر تکثیر میکروارگانیسم ها در تجهیزات تولیدی وجود داشته باشد.
خدمات شناسایی شیمیایی ما عبارتند از:
خصوصیات شیمیایی مواد
(ISO 10993-18, 19)
شناسایی و تعیین کمیت محصولات تخریب شده
(ISO 10993-13, 14, 15)
تعیین میزان مصرف قابل تحمل برای مواد قابل استخراج
(ISO 10993-17)
ارزیابی ریسک و ارزیابی سم شناسی
ما به شما کمک می کنیم تا ارزیابی های خطر و سم شناسی را انجام دهید تا به درک مشخصات ایمنی محصول دستگاه پزشکی کمک کنید. چنین پروفایلهایی میتوانند برای انجام آزمایشهای تحلیلی اضافی برای تحقیقات بیشتر در مورد موجودیتهای ناشناخته، برای هدایت استراتژیهای برنامه زیست سازگاری یا ترکیب آن با دادههای پیش بالینی برای ارزیابی ریسک جامع استفاده شوند. این ارزیابیها بر اساس ISO 10993-17 برای شناسایی و ارزیابی انتقادی هرگونه دادههای سمیت موجود و قرار گرفتن در معرض انسان در محصول نهایی دستگاه پزشکی، ترکیبات شیمیایی، افزودنیها، رنگها، کمکهای پردازش و مواد قابل شستشو بالقوه است.
تست زیست سازگاری
ما طیف کاملی از تست های زیست سازگاری مورد نیاز صنعت تجهیزات پزشکی را ارائه می دهیم. علاوه بر انجام مطالعات بیولوژیکی بر اساس ماتریس ISO 10993، تفاهم نامه کتاب آبی FDA، الزامات MHLW، طبقه بندی USP پلاستیک ها، از جمله کلاس VI و سایر دستورالعمل های بین المللی، ما انواع روش ها یا مدل های جایگزین مبتنی بر سلول را تحت GLP ارائه می دهیم. بررسی اثرات خطرناک وسایل پزشکی طراحی استراتژی تست سفارشی مناسب بسته به مواد محصول، روشهای ساخت و هدف مطالعه انتخاب میشود. خدمات ما شامل روشهای تست استاندارد و همچنین روشهای جایگزین تست آزمایشگاهی یا خدمات جامع هیستوپاتولوژیک است. لیست زیر یک مرور مختصر از خدمات ما است. برای یک لیست جامع لطفا روی لینک بالا کلیک کنید.
سم شناسی ژنتیک
همسازگاری (مطالعات استاتیک و دینامیک)
حساس شدن
تست های تحریک و تحمل موضعی
مسمومیت حاد سیستمیک
تب زایی
مسمومیت تحت حاد، تحت مزمن و مزمن
کاشت
کاشت در ترکیب با سمیت سیستمیک
ما با واقعیت ها و الزامات تجاری، از راه اندازی تا شرکت های چندملیتی تجهیزات پزشکی آشنا هستیم. مشتریان ما می توانند مطمئن باشند که PSL بهترین استراتژی تست را برای دستگاه های پزشکی شما در ارتباط با آخرین روندهای علمی ارائه می دهد.

مطالعات پل زدن
PSL همچنین مطالعات پل زدنی را برای تعیین پیشینه علمی برای ارزیابی بیولوژیکی یک دستگاه پزشکی انجام می دهد.
این مطالعات اطلاعات ضروری را برای ارزیابی خطرات و منافع و همچنین دستیابی به اجرای اخلاقی ارزیابی برنامه ریزی شده مطابق با مقررات رفاه حیوانات (یعنی ISO 10993-2) ارائه می دهد. زیست سازگاری از طریق گزارش های کارشناسی بر اساس داده های مواد و ادبیات، همراه با نتایج واقعی مطالعه ارزیابی می شود.
برای اینکه سازندگان تجهیزات پزشکی بتوانند این ایمنی را ثابت کنند، آنالیزهای آزمایشگاهی به طور منظم انجام می شود. به خصوص پس از معرفی مقررات جدید تجهیزات پزشکی (MDR)، سازندگان باید ارزیابی کنند که کدام آنالیزها باید اصلاً برای محصولشان انجام شود و کدام روشها اعمال میشوند. ردیابی این امر گاهی نه تنها برای تولیدکنندگان دشوار است، بلکه زمان و منابع زیادی نیز دارد.
بنابراین، شبکه جهانی آزمایشگاه نیکوفارمد طیف کاملی از خدمات تست معتبر دستگاه های پزشکی را مطابق با ISO 17025، FDA ایالات متحده و سایر مقررات بین المللی و همچنین مقررات بازنگری شده تجهیزات پزشکی اتحادیه اروپا ارائه می دهد.
با کمک مشاوره فردی توسط کارشناسان ما، تجزیه و تحلیل مناسب برای محصول شما را پیدا می کنیم و شما را در مسیر انطباق و همچنین کنترل کیفیت و تضمین تجهیزات پزشکی و تجهیزات پزشکی شما همراهی می کنیم.
آزمایشگاههای تست دستگاههای پزشکی گروه نیکوفارمد بر اساس استاندارد DIN EN ISO/IEC 17025 برای آزمایشهای بیولوژیکی و میکروبیولوژیکی-بهداشتی دستگاههای پزشکی معتبر هستند.
برآوردن الزامات نظارتی در دنیای متنوع تجهیزات پزشکی نیاز به مدیریت ماهرانه پروژه دارد. این می تواند یک کار دشوار و پیچیده باشد. شما باید نیازهای بسیاری از احزاب مختلف را متعادل کنید و در عین حال در حد بودجه باقی بمانید و ضرب الاجل های فشرده را رعایت کنید. نیازهای بالینی و ایمنی دستگاه بسیار مهم است و باید نشان داده شود. همکاری با فناوری های مهندسی پزشکی تضمین می کند که این بخش از پروژه شما به طور کارآمد و روان اجرا می شود. تکنسین های ما اغلب در حال ابداع پروتکل های پیچیده تحت فشار هستند و منابع کاملی برای اطمینان از تحویل سریع کار آزمایشی در اختیار دارند. ما نمیتوانیم نتایج را تضمین کنیم یا زمان ماندن در یک آزمایش را کوتاه کنیم، اما میتوانیم از دقت و کارایی اطمینان حاصل کنیم.
برای آزمایش دستگاه پزشکی خود با نیکوفارمد شریک شوید و ما قول می دهیم:
نقل قول های سریع و رقابتی
شروع سریع پروژه
دسترسی سریع به تجهیزات
تحویل و گزارش کارآمد
ما طبق ISO 17025 و GMP کار می کنیم. هنگامی که یک قرارداد برقرار شد ما با یک پروتکل برای تأیید یا نظر شما ظرف چند روز پاسخ خواهیم داد.
آزمایش دستگاه پزشکی فرآیندی است که نشان می دهد دستگاه در هنگام استفاده به طور قابل اعتماد و ایمن عمل می کند. در توسعه محصول جدید، آزمایش اعتبارسنجی طراحی گسترده اعمال می شود. این شامل آزمایش عملکرد، سمیت و آنالیز شیمیایی و گاهی اوقات عوامل انسانی یا حتی آزمایش بالینی است. آزمایش تضمین کیفیت مداوم معمولاً محدودتر است. این معمولاً شامل بررسی ابعادی، برخی آزمایشهای عملکردی و تأیید بستهبندی میشود.
ما دستگاه های پزشکی را می شناسیم
نیکوفارمد با انجام هزاران پروژه از شرکت های تجهیزات پزشکی در سراسر جهان پشتیبانی می کند. مهندسان کلیدی ما قبلاً در توسعه دستگاههای پزشکی برای تولیدکنندگان داروهای بیهوشی بلو چیپ مشارکت داشتهاند. در نتیجه، ما در مورد دستگاه های پزشکی، مکانیک دستگاه ها و الزامات نظارتی آنها می دانیم. مهمتر از همه، ما می دانیم که چگونه تجزیه و تحلیل ریسک را در محصول شما اعمال کنیم و نتیجه را برای ارائه خدمات تأیید و تأیید طراحی سریع و مقرون به صرفه اعمال کنیم.
شما از این دانش درونی بهره مند می شوید که با تجربه آزمایشی گسترده با همه کلاس های دستگاه و در بسیاری از برنامه ها به دست می آید.
ازمایش عملکرد
آزمایشگاه ما دارای تجربه گسترده ای در برخورد با طیف گسترده ای از دستگاه های پزشکی، از تماس سطحی گرفته تا ایمپلنت های دائمی و همچنین محصولات دارورسانی از تزریق کننده های خودکار گرفته تا اسپری ها و کرم ها است. تست آزمایشگاهی - ادامه مطلب...
تست مواد
خصوصیات مواد کاربردهای زیادی در توسعه و تولید تجهیزات پزشکی دارد.
این آنالیز شیمیایی مواد برای شناسایی «اثر انگشت» است. این اطلاعات سپس برای به حداقل رساندن آزمایش سم شناسی طرح های جدید و همچنین برای تغییرات تولید و طراحی استفاده می شود. شناسایی شیمیایی باید در مورد مواد خام ورودی و در تولیدات لات به لات نیز اعمال شود. نیکو فارمد طیف گسترده ای از تجهیزات تجزیه و تحلیل شیمیایی را برای کاربرد دانش مشخصه در اختیار دارد. این روش ها به همان اندازه برای مطالعه بقایای تمیز کردن و انتقال مواد قابل شستشو از بسته بندی و برچسب گذاری قابل استفاده هستند.
تست زیست سازگاری
دستگاه های پزشکی با توجه به طبقه بندی آنها به درجات مختلفی از آزمایش زیست سازگاری نیاز دارند. منبع اصلی راهنمایی در مورد الزامات ضروری برای ایمنی بیولوژیکی ISO 10993 - ارزیابی بیولوژیکی تجهیزات پزشکی است. این استاندارد دستگاهها را برحسب تهاجمی بودن و مدت زمان تماس با بیمار تعریف میکند، که متعاقباً تعیین میکند تولیدکنندگان چه سطحی از تستهای ایمنی را قبل از عرضه دستگاه خود به بازار باید با موفقیت انجام دهند.
تست زیست سازگاری دستگاه های پزشکی – ISO 10993
زیست سازگاری، طبق تعریف، اندازه گیری میزان سازگاری یک دستگاه یا ماده با یک سیستم بیولوژیکی است. استاندارد ISO 10993-1: 2018 زیست سازگاری را به عنوان "توانایی یک دستگاه یا ماده پزشکی برای عملکرد با پاسخ میزبان مناسب در یک برنامه خاص" تعریف می کند.
هدف از انجام تست زیست سازگاری تعیین تناسب دستگاه برای استفاده انسانی و دیدن اینکه آیا استفاده از دستگاه می تواند اثرات فیزیولوژیکی بالقوه مضری داشته باشد یا خیر است. همانطور که توسط سازمان بین المللی استاندارد (ISO) بیان شده است: "هدف اولیه این بخش از ISO 10993 محافظت از انسان در برابر خطرات احتمالی ناشی از استفاده از وسایل پزشکی است." (ISO 10993-1:2018). قبل از انجام تست زیست سازگاری، برای سازنده مهم است که درک بهتری از مواد دستگاه، ساخت دستگاه، استریل کردن و سایر فرآیندها به دست آورد. استاندارد ISO 10993-1:2018 بر خصوصیات شیمیایی قبل از اقدام به آزمایش زیست سازگاری in vitro و in vivo تاکید دارد.
فرآیند کلی تست زیست سازگاری را می توان به سه مرحله تقسیم کرد: برنامه ریزی، آزمایش و ارزیابی داده ها. در مرحله برنامه ریزی باید اطلاعات مربوط به مواد مورد استفاده برای ساخت دستگاه جمع آوری شود. یک طرح ارزیابی بیولوژیکی (BEP) نیز باید ایجاد شود که نوع آزمایش مورد نیاز را تعیین می کند. برای اطلاعات بیشتر در مورد چگونگی تعیین اینکه کدام آزمایش مورد نیاز است، به ابزار برنامه ریزی زیست سازگاری PBL (BioPT) مراجعه کنید. آزمایش معمولاً با غربالگری آزمایشگاهی با انجام آزمایش سمیت سلولی شروع می شود. آزمایش قابل استخراج قابل استخراج، یا خصوصیات شیمیایی، نیز معمولاً قبل از آزمایش in vivo انجام می شود. سمیت سلولی، خصوصیات شیمیایی و آزمایش زیست سازگاری درون تنی در زیر توضیح داده شده است.
سیتوتوکسیسیتی در شرایط آزمایشگاهی – ISO 10993-5
سمیت سلولی یک آزمایش زیست سازگاری است که بر روی سلول های پستانداران در کشت انجام می شود. سه آزمایش سمیت سلولی در شرایط آزمایشگاهی وجود دارد که PBL انجام می دهد: MEM Elution، Agarose Overlay و Direct Contact. آزمایش سمیت سلولی سمیت یا مواد و مواد شیمیایی را با قرار دادن مستقیم سلول های کشت شده در معرض نمونه یا با تهیه عصاره از نمونه و قرار دادن سلول ها در معرض عصاره ارزیابی می کند. لطفاً برای جزئیات بیشتر از صفحه آزمایش سمیت سلولی ما دیدن کنید.
دستگاه های استخراج و تخلیه - ISO 10993-18
به طور معمول، تعیین خصوصیات شیمیایی و تجزیه و تحلیل اجزای یک دستگاه، همچنین به عنوان آزمایش قابل استخراج و شسته شدن دستگاه، قبل از هر آزمایش بیولوژیکی انجام می شود. این شامل استخراج مواد قابل شستشو از دستگاه یا اجزا در دمای بالا و تجزیه و تحلیل عصاره ها با استفاده از انواع ابزار دقیق است. ارزیابی خطر های سم شناسی بر روی عصاره های قابل شستشو برای مواد شیمیایی مضر و یا سمی انجام می شود. این جنبه از زیست سازگاری از ISO 10993-18، مشخصات شیمیایی مواد پیروی می کند و در چند سال گذشته اهمیت فزاینده ای پیدا کرده است.
مقالات بیشتر:
تست همولیز – ASTM F756
ما آزمایشهای همولیز را از طریق روشهای مستقیم و استخراج انجام میدهیم تا اثرات نامطلوب دستگاههای پزشکی، مواد شستهشونده و بیومواد را بر روی خون خرگوش ارزیابی کنیم. این سنجش برای ارزیابی همسازگاری دستگاههای پزشکی و بیومواد بر اساس استاندارد بینالمللی ISO 10993-4:2017 و ASTM F756 مناسب است.
تست زیست سازگاری در VIVO
هنگامی که آزمایش آزمایشگاهی کامل شد، آزمایش بیولوژیکی in vivo انجام می شود، با وسعت نوع آزمایش که بر اساس استفاده مورد نظر دستگاه انجام می شود. آزمایش In vivo می تواند از آزمایش تحریک پوست گرفته تا تست حساسیت، آزمایش کاشت و تست سمیت سیستمیک باشد. بسته به دادههای آزمایشی خاص مورد نیاز، زمان انجام آزمایشها میتواند از سه هفته تا بیش از چند ماه متغیر باشد. مطالعات سمیت سیستمیک تحت مزمن یا مزمن می تواند حتی بیشتر طول بکشد.
آزمایش کشت باکتری چیست؟
باکتری ها موجودات تک سلولی هستند. انواع مختلفی از باکتری ها وجود دارد. آنها در سراسر بدن و پوست زندگی می کنند. برخی از انواع باکتری ها بی ضرر و حتی مفید هستند. برخی دیگر باعث عفونت و بیماری می شوند.
آزمایش کشت باکتری می تواند باکتری های مضر را در بدن یا روی بدن که ممکن است باعث بیماری شوند، شناسایی کند. برای انجام آزمایش، باید نمونه ای از خون، ادرار، پوست یا سایر بافت ها تهیه کنید. نوع نمونه بستگی به جایی دارد که عفونت به نظر می رسد.
برای اینکه بفهمید چه نوع باکتری ممکن است داشته باشید، یک متخصص سلامت تعداد زیادی از سلول های باکتری را بررسی می کند. برای این کار، نمونه شما به آزمایشگاه فرستاده می شود تا زمانی که باکتری کافی برای آزمایش وجود داشته باشد، در آنجا رشد می کند. به طور کلی، نتایج در عرض چند روز آماده می شود. با این حال، برخی از انواع باکتریها به کندی تکثیر میشوند، بنابراین نتایج شما ممکن است چند روز یا بیشتر طول بکشد.
برای چه چیزی از این تست استفاده می کنید؟
آزمایش های کشت باکتری برای تشخیص انواع خاصی از عفونت استفاده می شود. رایج ترین انواع و کاربرد آنها عبارتند از:
فرهنگ گلو
برای تشخیص یا رد عفونت استرپتوکوکی استفاده می شود
روش تست:
یک متخصص بهداشت یک سواب مخصوص را برای گرفتن نمونه از پشت گلو و لوزه ها وارد می کند.
کشت ادرار
برای تشخیص عفونت ادراری و شناسایی باکتری های عامل عفونت استفاده می شود.
روش تست:
شما یک نمونه ادرار استریل را در ظرفی به دنبال دستورالعمل های خاص می دهید
کشت خلط
خلط مخاط غلیظی می باشد که از ریه ها سرفه می شود. با تف یا بزاق متفاوت است.
برای تشخیص عفونت های باکتریایی یا قارچی دستگاه تنفسی مانند پنومونی، سل، برونشکتازی و هیستوپلاسموز باکتریایی استفاده می شود.
روش تست:
نمونه خلط را معمولاً با سرفه کردن یک ظرف مخصوص تحویل می دهید. در موارد خاص، برای گرفتن نمونه نیاز به برونکوسکوپی دارید. برونکوسکوپی شامل قرار دادن یک لوله انعطاف پذیر در بینی یا دهان به داخل ریه است.
کشت خون
برای تشخیص وجود عفونت های باکتریایی یا قارچی در خون استفاده می شود
روش تست:
پزشک یا متخصص بهداشت نمونه خون می گیرد. نمونه ها بیشتر از ورید بازو گرفته می شوند
فرهنگ مدفوع
مدفوع به عنوان ماده مدفوع نیز شناخته می شود.
برای تشخیص عفونت های باکتریایی در دستگاه گوارش از جمله مسمومیت غذایی استفاده می شود. از آنجایی که بسیاری از چیزها میتوانند باعث بیماریهای گوارشی شوند، این آزمایش اغلب با آزمایشهای دیگر انجام میشود تا ویروسها و انگلهایی را که میتوانند علائم ایجاد کنند، جستجو کنند.
روش تست:
شما یک نمونه مدفوع را در یک ظرف تمیز به دنبال دستورالعمل های متخصص مراقبت های بهداشتی خود می دهید.
کشت زخم
برای تشخیص عفونت در زخم های باز یا جراحات سوختگی استفاده می شود.
روش تست:
یک متخصص بهداشت از یک سواب مخصوص برای گرفتن نمونه ای از سلول ها یا چرک زخم استفاده می کند. برای زخم های عمیق، ممکن است از یک سرنگ برای کشیدن مایع استفاده شود، یا ممکن است بیوپسی برای برداشتن تکه ای از بافت از زخم انجام شود.
چرا به آزمایش کشت باکتری نیاز دارم؟
اگر علائم عفونت باکتریایی دارید، متخصص مراقبت های بهداشتی شما ممکن است آزمایش کشت باکتریایی را تجویز کند. علائم بسته به نوع عفونت مختلف است.
چرا باید اینقدر منتظر نتایجم باشم؟
آزمایش کشت باکتری به تعداد زیادی سلول برای شناسایی صحیح نوع باکتری که ممکن است باعث عفونت شود نیاز دارد. اکثر نمونه ها سلول های کافی برای این کار را ندارند. بنابراین، نمونه شما به آزمایشگاهی فرستاده می شود که به سلول ها اجازه می دهد تا زمانی که تعداد کافی برای انجام آزمایش وجود داشته باشد، رشد کنند. اکثر باکتری های عامل بیماری در یک یا دو روز آماده آزمایش خواهند بود، اما برخی از انواع باکتری ها پنج روز یا بیشتر طول می کشد تا سلول های کافی رشد کنند.
آیا جهت آمادگی در آزمایش باید اقدامی انجام دهم؟
انواع مختلفی از آزمایش های کشت باکتری وجود دارد. از متخصص مراقبت های بهداشتی خود بپرسید که آیا کاری برای آماده شدن برای آزمایش خود باید انجام دهید.
آیا این آزمایش خطراتی دارد؟
هیچ خطر شناخته شده ای در ارتباط با گرفتن نمونه سواب، انجام آزمایش خون، یا دادن نمونه ادرار یا مدفوع وجود ندارد.
مقالات بیشتر:
این نتایج چه معنی ای می دهد؟
اگر باکتری های مضر در نمونه شما یافت شد، معمولاً به این معنی است که شما یک عفونت باکتریایی دارید. متخصص مراقبتهای بهداشتی شما ممکن است آزمایشهای بیشتری را برای تأیید تشخیص یا تعیین میزان جدی بودن عفونت تجویز کند.
متخصص مراقبت های بهداشتی شما همچنین ممکن است آزمایشی را تجویز کند تا مشخص شود کدام دارو برای درمان نوع باکتری شما بهتر عمل می کند. این تست حساسیت آنتی بیوتیکی یا "تست حساسیت" نامیده می شود. برای تعیین میزان حساسیت باکتری ها به انواع مختلف آنتی بیوتیک ها استفاده می شود. اگر در مورد نتایج خود سؤالی دارید، با متخصص مراقبت های بهداشتی خود صحبت کنید.
آیا باید چیز دیگری در مورد آزمایش کشت باکتری نیز بدانم؟
اگر نتایج نشان داد که عفونت باکتریایی ندارید، نباید آنتی بیوتیک مصرف کنید. آنتی بیوتیک ها عفونت های باکتریایی را فقط درمان می کنند. مصرف آنتیبیوتیکها در زمانی که به آنها نیاز ندارید، به شما کمک نمیکند تا احساس بهتری داشته باشید و میتواند منجر به یک مشکل جدی به نام مقاومت آنتیبیوتیکی شود.
مقاومت آنتیبیوتیکی به باکتریهای مضر اجازه میدهد تا تغییر کنند و آنتیبیوتیکها را کمتر یا اصلاً مؤثر کنند. این می تواند برای شما و جامعه شما خطرناک باشد، زیرا باکتری های مقاوم به آنتی بیوتیک می توانند به افراد دیگر سرایت کنند.





